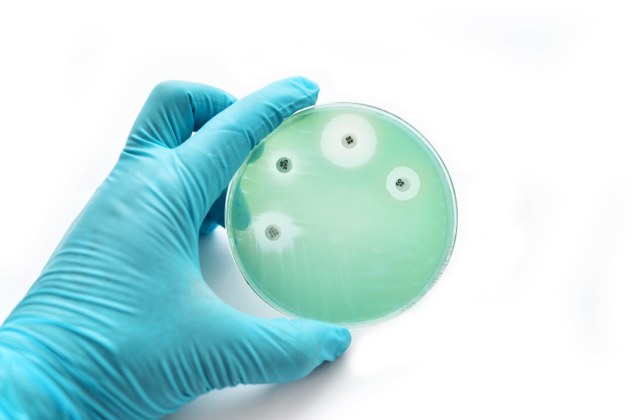

Objetivo é discutir o uso racional de medicamentos com profissionais da área da saúde humana, animal e ambiental
Em razão da Semana Mundial de Conscientização Antimicrobiana, o Ministério da Saúde realiza, nesta terça (22) e quarta-feira (23), a partir de 15h, um evento online com o tema “Prevenindo juntos a resistência aos antimicrobianos”. O objetivo é discutir o uso racional de medicamentos com profissionais da área da saúde humana, animal e ambiental, além das ações e trabalhos relevantes para reduzir o surgimento e a disseminação de organismos resistentes a medicações. Interessados podem acompanhar pelo link http://webinar.aids.gov.br.
Segundo a Organização Pan-Americana da Saúde (Opas/OMS), a resistência antimicrobiana (RAM) ocorre quando microrganismos (bactérias, fungos, vírus e parasitas) sofrem alterações quando expostos a antimicrobianos (antibióticos, antifúngicos, antivirais, antimaláricos ou anti-helmínticos, por exemplo). A RAM é uma ameaça para os seres humanos, animais, plantas e meio ambiente e o combate é um esforço global.
Segundo a Secretaria de Vigilância em Saúde (SVS/MS), o Brasil possui ações relevantes, como o Plano de Ação Nacional de Prevenção e Controle da Resistência aos Antimicrobianos no Âmbito da Saúde Única. A Coordenação-Geral de Laboratórios de Saúde Pública (SVS/MS) é responsável por garantir que se mantenha a capacidade de tratar e prevenir doenças infecciosas com medicamentos seguros e eficazes, que sejam de qualidade assegurada e utilizados de forma responsável e acessível a todos que necessitam.
Na programação do evento estão previstas as seguintes participações:
- Rodrigo Rabelo, médico veterinário e CEO Intensivet Saúde Digital, participa com o tema “Uso racional de antimicrobianos em cães e gatos”;
- Luciana Sartori, médica veterinária e coordenadora do Subcomitê de Veterinária do Eucast, participa com o tema “BRCast vet”;
- Viviane Dias, médica infectologista e coordenadora da CCIH do Hospital Nossa Senhora das Graças, participa com o tema “’Stewardship’ de antimicrobianos”;
- Jônatas Cunha, biólogo e doutor em biologia molecular da UnB, participa com o tema “Ações do DAF/SCTIE no combate da resistência aos antimicrobianos”;
- Vivyanne Santiago, médica veterinária e consultora técnica na Coordenação-Geral de Vigilância de Zoonoses (SVS/MS), participa com o tema “Implantação de um grupo técnico interinstitucional de saúde única no Brasil”; e
- Juliana Calabria, bióloga, pós-doutorada em microbiologia ambiental e pós-doutorada em biodigestão anaeróbia, participa com o tema “Dimensão ambiental da resistência aos antimicrobianos: o papel das estações de tratamento de esgoto”.
Além da pasta da Saúde, também participam da abertura do webinário representantes da Opas/OMS, Organização das Nações Unidas para Alimentação e Agricultura (FAO), Organização Mundial para a Saúde Animal (WOAH), Ministério da Agricultura, Pecuária e Abastecimento (MAPA) e Agência Nacional de Vigilância Sanitária (Anvisa).